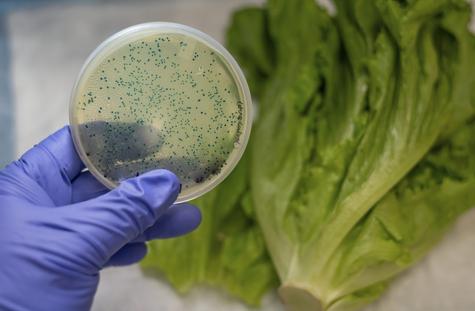

¿Cuáles son los peligros de NO lavar la LECHUGA y cómo lavarla correctamente
Es esencial lavar la lechuga para eliminar cualquier microorganismo que pueda contener.

La lechuga es uno de los vegetales más conocidos, no solo por su versatilidad como acompañamiento, sino también debido a sus numerosos beneficios para la salud. Pese a que la usamos cotidianamente, este vegetal puede representar un riesgo para la salud si no se maneja adecuadamente. A continuación, te contamos cuáles son los riesgos de no lavar correctamente la lechuga.
Únete a nuestro canal de Whatsapp¿Qué pasa si no lavo bien la lechuga?
No lavar adecuadamente la lechuga puede dar lugar principalmente a la propagación de microorganismos infecciosos, como la salmonela, la listeria o la Escherichia coli, según el portal web de “La Sexta”. Los especialistas señalan que estas bacterias pueden multiplicarse en el vegetal y, al ser ingerido, las personas más vulnerables pueden experimentar síntomas como diarrea, vómitos, malestar, entre otros.
¿Cómo lavar y desinfectar correctamente la lechuga?
- Para desinfectar correctamente la lechuga puedes seguir los siguientes pasos.
- Es crucial destacar que lo primero que debes hacer, antes incluso de entrar en contacto con la lechuga, es lavar adecuadamente tus manos. Debes limpiarlas minuciosamente con agua y jabón durante al menos 20 segundos. De esta manera, evitarás contaminar la lechuga al tocarla con las manos.
- El siguiente paso es sumergir las hojas en agua fría durante 1 o 2 minutos y añadir unas gotas de desinfectante para alimentos, como se indica en el portal web de “Gastrolab”. Otra alternativa es utilizar ingredientes naturales, como vinagre o bicarbonato de sodio, y dejar las hojas en remojo durante 15 o 20 minutos.
- Después, escurrir el agua y enjuagar hoja por hoja.
- Por último, desecha las hojas que estén oscuras o dañadas y, antes de servirlas, asegúrate de que estén bien secas. Si necesitas acelerar el proceso puedes utilizar papel de cocina.

Cuando desees servir la lechuga, es importante usar utensilios limpios para manipularla adecuadamente, ya que este proceso puede afectar su estado.
Te puede interesar: SI LA COMIDA SE HA QUEMADO, NO LA TIRES: PON EN PRÁCTICA ESTOS TRUCOS
¿Por qué no deberías cortar la lechuga con el cuchillo?
De preferencia, evita cortar la lechuga con un cuchillo común de cocina, ya que al entrar en contacto con el metal, se oxida y pierde ligeramente su sabor original, además de que se reducen sus nutrientes. La forma adecuada de cortarla es utilizando las manos, previamente lavadas de manera adecuada. También existen herramientas específicas para cortar la lechuga, como cuchillos especiales y tijeras de plástico. Lo importante es tratar de emplear utensilios metálicos.

¿Cómo conservar las lechugas?
Es aconsejable mantenerla en el refrigerador. Lo mejor es colocarla en el compartimento destinado a las frutas y verduras para que conserve su frescura por más tiempo. Además, puedes envolver la lechuga en papel toalla antes de guardarla en el refrigerador. De esta manera, las hojas absorberán el exceso de humedad sin deshidratarse.
Te puede interesar:
Más Notas
Ver más
Así puedes AFILAR las cuchillas de tu licuadora con HUEVOS, en minutos
Por Redacción Buenazo

¿Cómo guardar el pollo correctamente en el refrigerador? NO lo guardes en bolsas de plástico por esta razón
Por Redacción Buenazo













